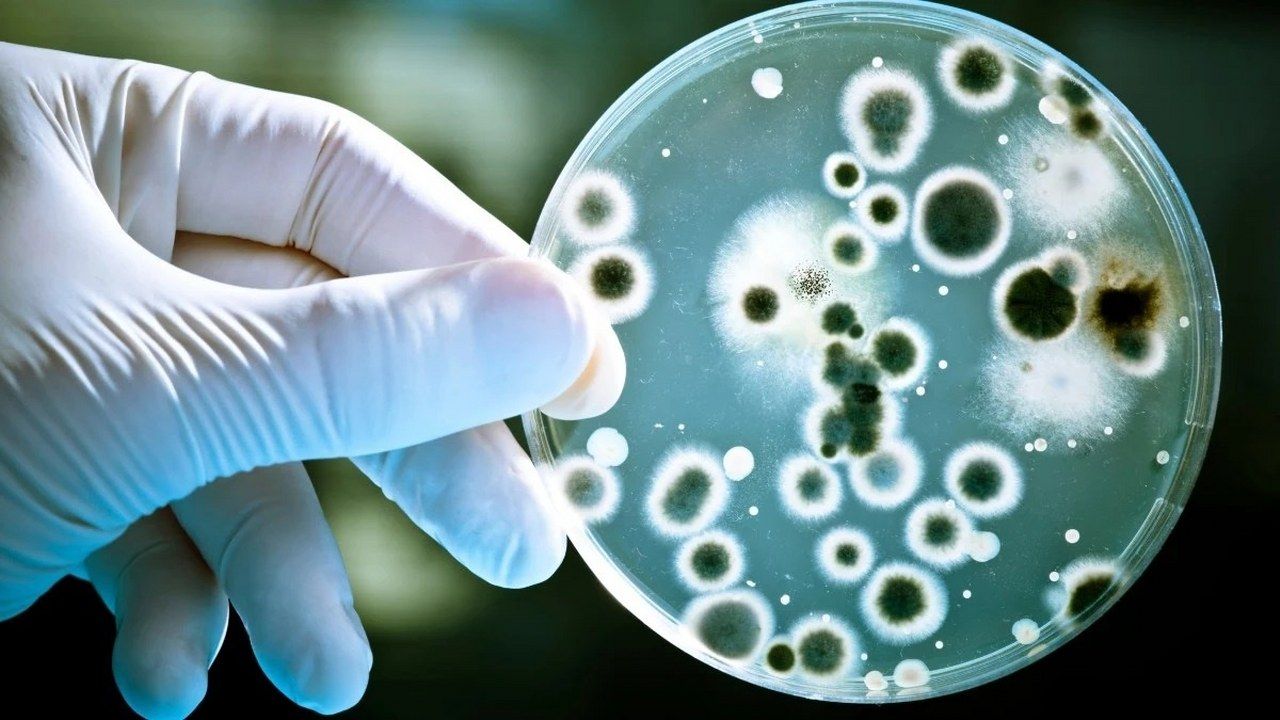

Doğal antibiyotik
- Şub- 2025 -9 ŞubatSAĞLIK

Tüketmeyen çok şey kaybediyor! Sarımsak en doğal antibiyotik
Sarımsak, sadece lezzetiyle değil, sağlığımıza sunduğu faydalarla da dikkat çekiyor. Bağışıklık sistemini güçlendiren, kalp sağlığını koruyan ve kanserle mücadele eden…
Devamını Oku » - 1 ŞubatErzincan - Genel

O Antibiyotik Raflardan Kaldırılıyor!
Bactrim isimli antibiyotiğin özellikle çocuklarda solunum yetmezliği ve akciğer sorunlarına yol açabileceği konusunda uzmanlardan uyarı geldi
Devamını Oku » - Ara- 2024 -28 AralıkSAĞLIK

Bakterilere karşı aşı geliştirme çalışmaları yapılıyor
Antibiyotiklere dirençli "Klebsiella pneumoniae" bakterisine karşı aşı geliştirme çalışmalarına başladı. DSÖ'nün uyarıları doğrultusunda yürütülen bu çalışma, küresel sağlık tehdidine karşı…
Devamını Oku » - 11 AralıkSAĞLIK

Narı zarıyla yiyin! Bakın neden?
Nar, güçlü antioksidan özellikleriyle bağışıklık sistemini güçlendirir, kalp sağlığını korur, kolesterol ve şekeri dengeler, kanser hücrelerinin gelişmesini engeller. Sağlığınızı korumanın…
Devamını Oku » - Kas- 2024 -27 KasımSAĞLIK

Okula giden çocuklarda kış enfeksiyonlarına davetiye çıkartmayın! Yapılan 10 hata
Kış mevsiminde çocukların enfeksiyonlara daha yatkın olması, ebeveynlerin yanlış tedavi yöntemleriyle sorunları büyütmesine neden olabiliyor. İşte okul döneminde sık yapılan…
Devamını Oku » - 23 KasımSAĞLIK

Gereksiz antibiyotik kullanımı tehdit oluşturuyor! Doğru kullanımın önemi çok büyük
Antibiyotiklerin yanlış ve gereksiz kullanımı, hem bireysel sağlık hem de halk sağlığı açısından büyük riskler oluşturuyor. Uzmanlar, antibiyotiklerin yalnızca doğru…
Devamını Oku » - 21 KasımSAĞLIK

İyileşmek için kullanıyoruz ama zarar da veriyor: Gereksiz kullanımdan kaçının
İyileşmek için kullandığımız antibiyotiklerin gereksiz kullanımları vücuda zarar verebilir. Peki yan etkileri neler?
Devamını Oku » - 16 KasımSAĞLIK

Antibiyotik değerinde! Kış aylarının vazgeçilmez lezzeti turşu gribe birebir!
Sonbahar ve kış aylarında sofraların vazgeçilmezi haline gelen turşu, hem lezzetli hem de sağlıklı. Ev yapımı turşuların faydalarını keşfedin ve…
Devamını Oku »